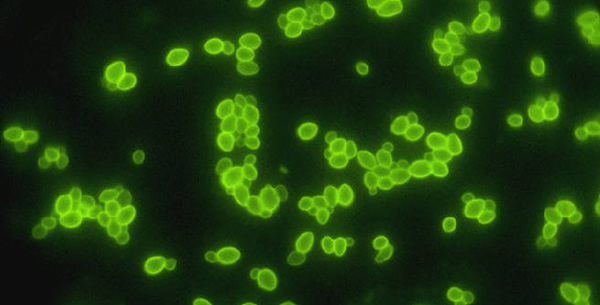

Imunofluorescentna tehnika (IF) se zasniva na primjeni antitjela obiljezenih nekom flurescentnom bojom- flurohromom koja se kovalentno vezuje za antitjela ne mjenjajuci im funkcionalnost i imunsku specificnost.
Ovi obiljezivaci emituju karakteristicnu svjetlost ako se izloze dejstvu svjetla odredjene talasne duzine. Ova tehnika se koristi za detekciju virusnih antigena u bolesnickom materijalu za ranu detekciju virusne replikacije u kuturi celija.
Postoje dvije osnovne varijante:
- Direktna imunofluorescencija DIF: Gdje se koristi specificno antitjelo obiljezeno flurohromom koje reaguje direktno sa antigenom.
- Indirektna imunofluorescencija IIF: Koristi se antihumani imunoglobulin obiljezen nekim flurohromom.

Be the first to comment